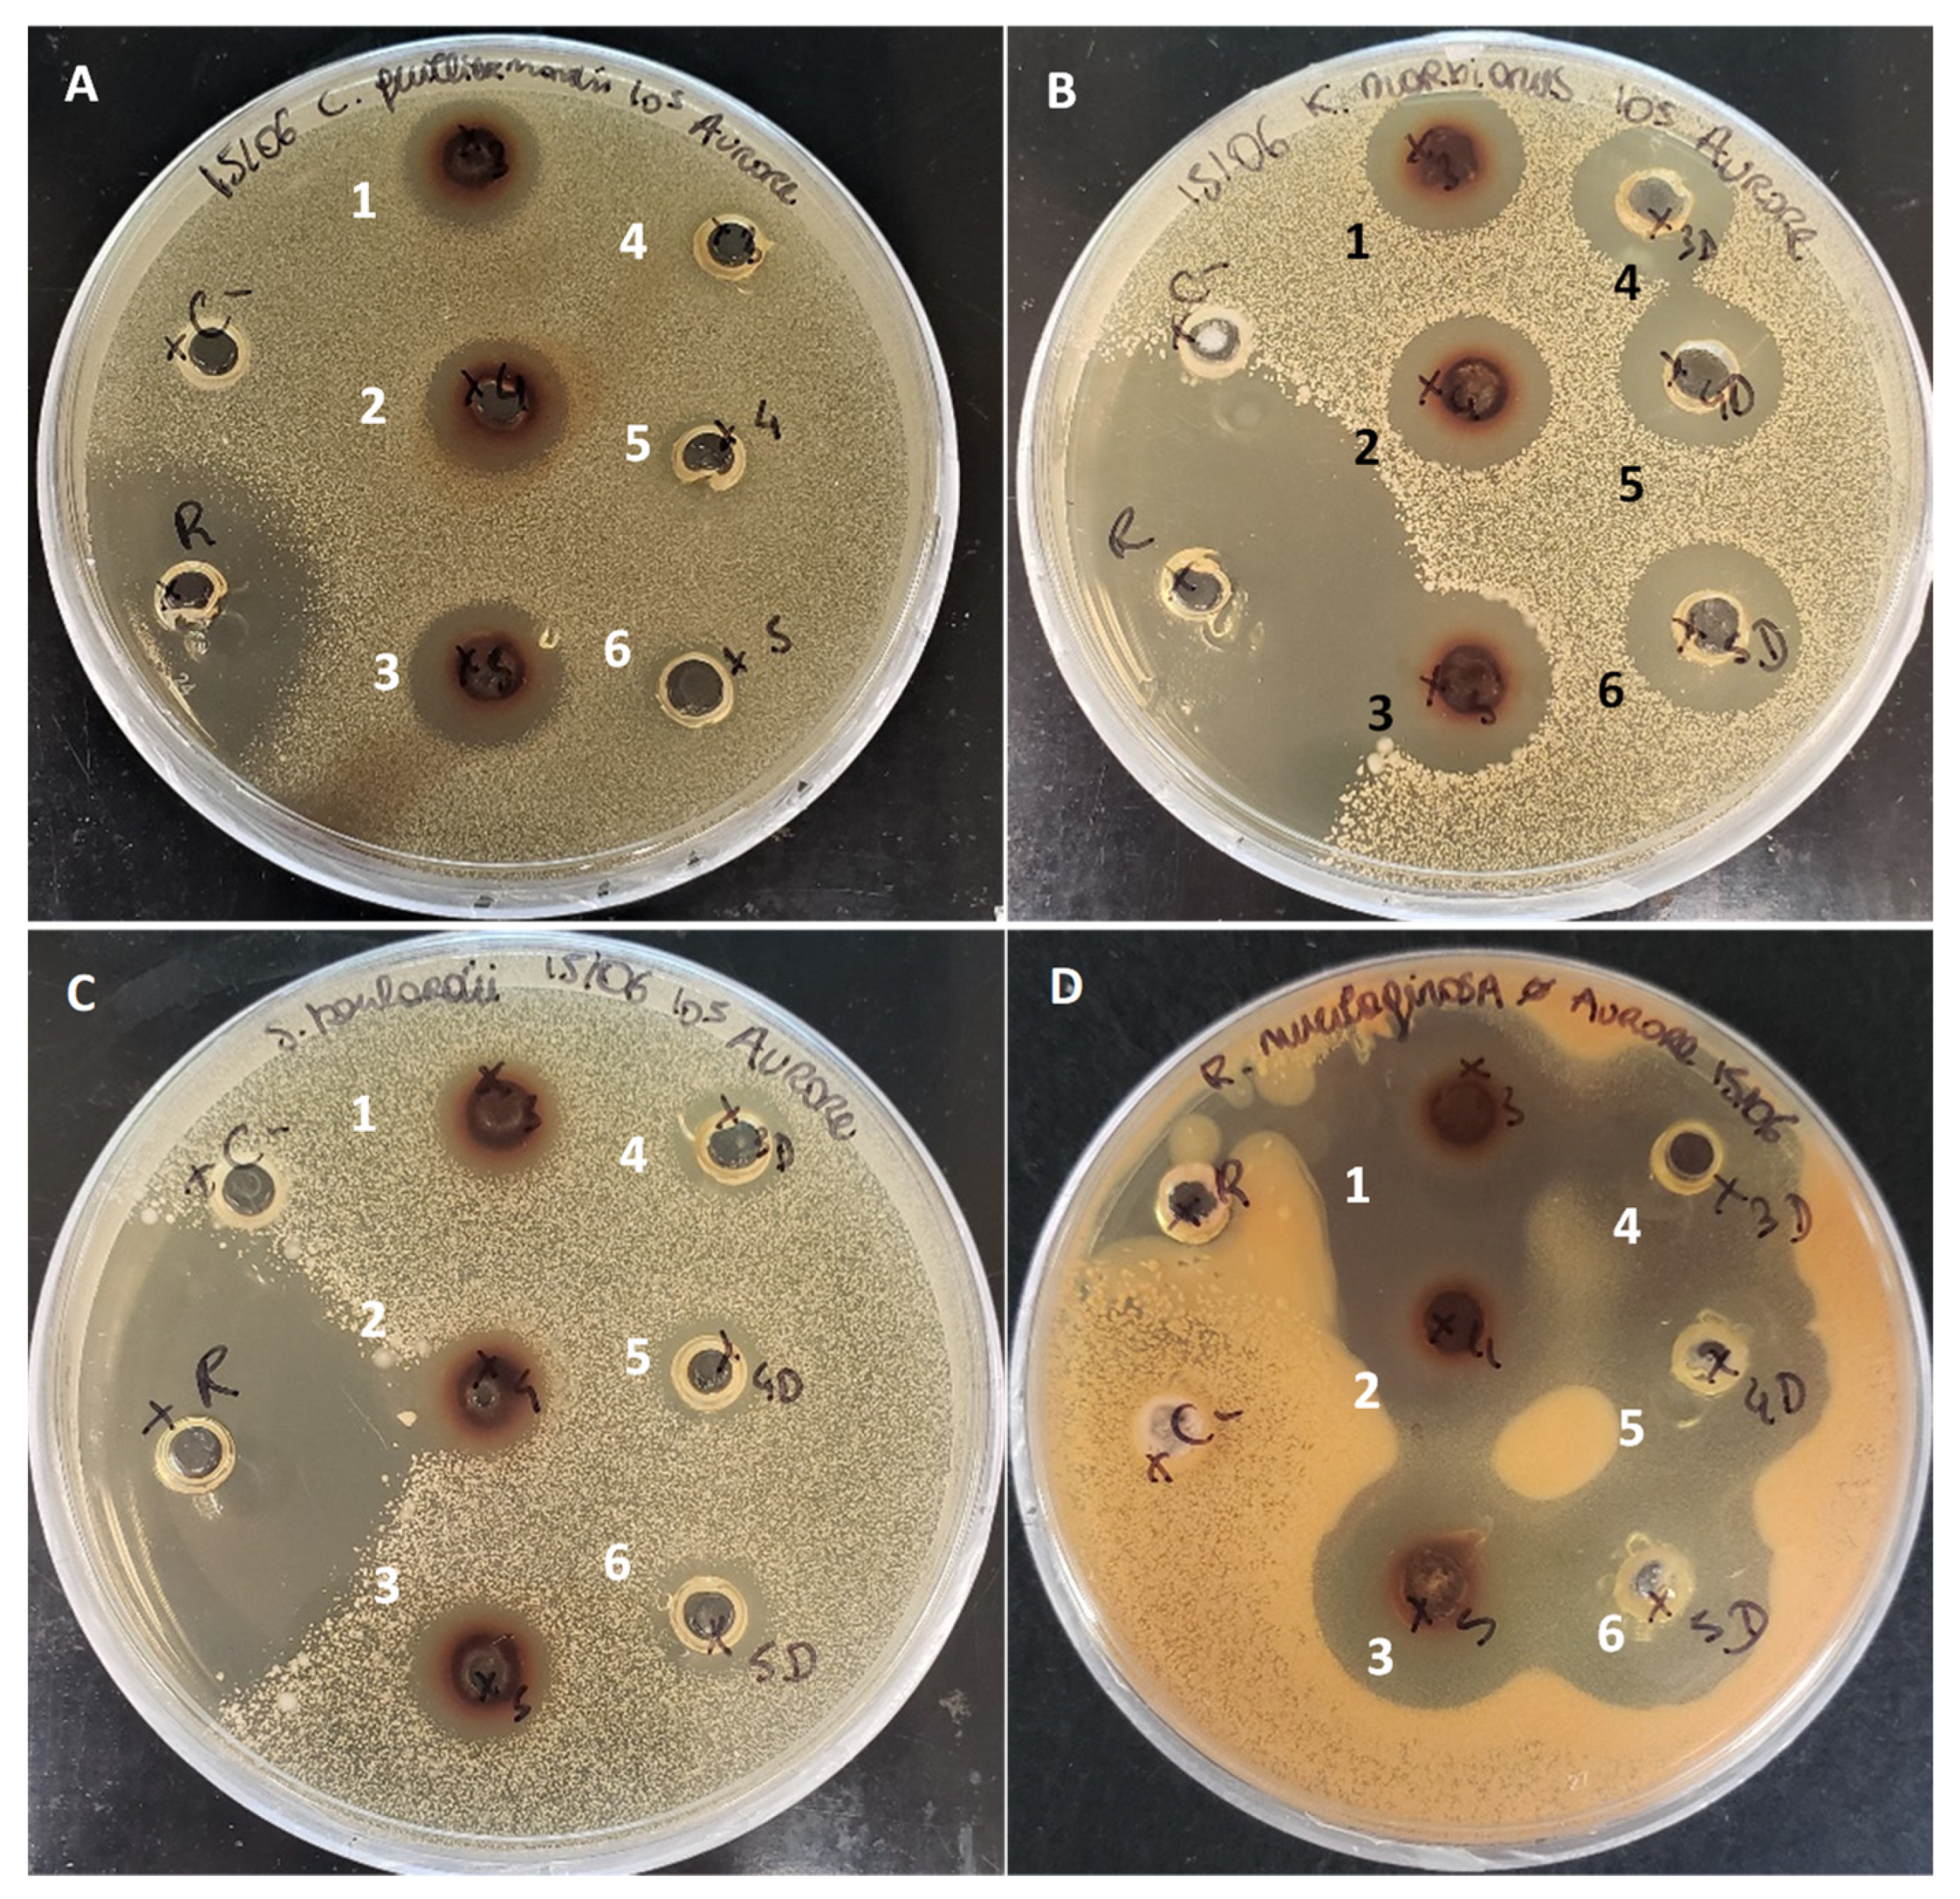
Foods 11 04035 g006

How Discoloration of Porcine Cruor Hydrolysate Allowed the Identification of New Antifungal Peptides
Abstract
1. Introduction
2. Materials and Methods
2.1. Porcine Cruor Preparation
2.2. Enzymatic Hydrolysis of Porcine Cruor
2.2.1. Quantification of Hemoglobin Concentration
2.2.2. Peptic Hydrolysis Process
2.3. Discoloration of Porcine Cruor Hydrolysate
2.4. Analyses
2.4.1. Determination of the Degree of Hydrolysis
2.4.2. Protein Content
2.4.3. RP-UPLC-MS/MS Peptide Profiles Analysis
2.5. Synthesized Peptides
2.6. Antimicrobial Assays
2.6.1. Microorganisms
2.6.2. Agar Diffusion Assay
2.6.3. Determination of the Minimal Inhibitory, Bactericidal, and Fungicidal Concentrations
2.6.4. Fractional Inhibitory Concentration Index (FICI)
2.7. Statistical Analyses
3. Results and Discussion
3.1. Porcine Cruor Hydrolysis
3.1.1. Degree of Hydrolysis
3.1.2. Protein Content
3.2. Peptide Population and Identification
3.2.1. Mapping and Comparison of Peptides, before Discoloration
3.2.2. Comparison of RP-UPLC-MS/MS Raw and Discolored Profiles
3.2.3. Comparison of the Identified Peptides
- (a)
- Common peptides between raw and discolored hydrolysates
- (b)
- Difference in peptides between raw and discolored hydrolysates
3.3. Antimicrobial Activities
3.3.1. Antibacterial Activity of the Hydrolysates
3.3.2. Antifungal Activity
- (a)
- Agar diffusion
- (b)
- Minimal Inhibition Concentration (MIC) and Minimal Fungicidal Concentration (MFC)
- (c)
- Antifungal activity of the synthesized peptides
4. Conclusions
Supplementary Materials
Author Contributions
Funding
Data Availability Statement
Acknowledgments
Conflicts of Interest
References
- Canadian Pork Council. Foreign Trade. Available online: https://www.cpc-ccp.com/foreign-trade (accessed on 30 September 2022).
- MAPAQ. Élevage de Porc. Available online: https://www.mapaq.gouv.qc.ca/fr/Productions/Production/Pages/Porc.aspx (accessed on 26 April 2020).
- Government of Ontario Chapitre 7-Élimination des Déchets de Production de Viande; Ministère Procureur Général: Toronto, ON, Canada, 2019; p. 46.
- Agriculture and Agri-Food Canada Porc. Available online: https://agriculture.canada.ca/fr/secteurs-agricoles-du-canada/production-animale/information-marche-viandes-rouges/porc (accessed on 26 May 2022).
- Government of New-Brunswick Lignes Directrices Régissant l’élimination Des Déchets d’abattoirs et Des Carcasses; Department of Agriculture, Aquaculture and Fisheries: Fredericton, NB, Canada, 2014.
- Przybylski, R.; Firdaous, L.; Châtaigné, G.; Dhulster, P.; Nedjar, N. Production of an antimicrobial peptide derived from slaughterhouse by-product and its potential application on meat as preservative. Food Chem. 2016, 211, 306–313. [Google Scholar] [CrossRef] [PubMed]
- Román, S.; Sánchez-Siles, L.M.; Siegrist, M. The importance of food naturalness for consumers: Results of a systematic review. Trends Food Sci. Technol. 2017, 67, 44–57. [Google Scholar] [CrossRef]
- Zhou, G.; Xu, X.; Liu, Y. Preservation technologies for fresh meat—A review. Meat Sci. 2010, 86, 119–128. [Google Scholar] [CrossRef] [PubMed]
- Leyva Salas, M.; Mounier, J.; Valence, F.; Coton, M.; Thierry, A.; Coton, E. Antifungal Microbial Agents for Food Biopreservation—A Review. Microorganisms 2017, 5, 37. [Google Scholar] [CrossRef]
- Abou-Diab, M.; Thibodeau, J.; Deracinois, B.; Flahaut, C.; Fliss, I.; Dhulster, P.; Bazinet, L.; Nedjar, N. Bovine Hemoglobin Enzymatic Hydrolysis by a New Eco-Efficient Process-Part II: Production of Bioactive Peptides. Membranes 2020, 10, 268. [Google Scholar] [CrossRef]
- Hedhili, K.; Dimitrov, K.; Vauchel, P.; Sila, A.; Chataigné, G.; Dhulster, P.; Nedjar, N. Valorization of cruor slaughterhouse by-product by enzymatic hydrolysis for the production of antibacterial peptides: Focus on α 1–32 family peptides mechanism and kinetics modeling. Bioprocess Biosyst. Eng. 2015, 38, 1867–1877. [Google Scholar] [CrossRef]
- Ivanov, V.T.; Karelin, A.A.; Philippova, M.M.; Nazimov, I.V.; Pletnev, V.Z. Hemoglobin as a Source of Endogenous Bioactive Peptides: The Concept of Tissue-Specific Peptide Pool. Pept. Sci. 1997, 43, 171–188. [Google Scholar] [CrossRef]
- Nedjar-Arroume, N.; Zouari, O.; Przybylski, R.; Hannioui, M.; Sion, L.; Dhulster, P. High Added-Value Co-Product: The Porcine Cruor is an Attractive Source of Active Peptides. J. Nutr. Health Food Sci. 2020, 8, 1–9. [Google Scholar] [CrossRef]
- Wei, J.-T.; Chiang, B.-H. Bioactive peptide production by hydrolysis of porcine blood proteins in a continuous enzymatic membrane reactor. J. Sci. Food Agric. 2008, 89, 372–378. [Google Scholar] [CrossRef]
- Adje, E.Y.; Balti, R.; Kouach, M.; Dhulster, P.; Guillochon, D.; Nedjar-Arroume, N. Obtaining antimicrobial peptides by controlled peptic hydrolysis of bovine hemoglobin. Int. J. Biol. Macromol. 2011, 49, 143–153. [Google Scholar] [CrossRef]
- Chang, C.-Y.; Wu, K.-C.; Chiang, S.-H. Antioxidant properties and protein compositions of porcine haemoglobin hydrolysates. Food Chem. 2007, 100, 1537–1543. [Google Scholar] [CrossRef]
- Nedjar-Arroume, N.; Dubois-Delval, V.; Adje, E.Y.; Traisnel, J.; Krier, F.; Mary, P.; Kouach, M.; Briand, G.; Guillochon, D. Bovine hemoglobin: An attractive source of antibacterial peptides. Peptides 2008, 29, 969–977. [Google Scholar] [CrossRef] [PubMed]
- Fogaça, A.C.; da Silva, P.I.; Miranda, M.T.M.; Bianchi, A.G.; Miranda, A.; Ribolla, P.E.; Daffre, S. Antimicrobial Activity of a Bovine Hemoglobin Fragment in the Tick Boophilus microplus. J. Biol. Chem. 1999, 274, 25330–25334. [Google Scholar] [CrossRef] [PubMed]
- Pereira, A.; Gomide, L.; Cecon, P.; Fontes, E.; Fontes, P.; Ramos, E.; Vidigal, J. Evaluation of mortadella formulated with carbon monoxide-treated porcine blood. Meat Sci. 2014, 97, 164–173. [Google Scholar] [CrossRef]
- Toldrà, M.; Parés, D.; Saguer, E.; Carretero, C. Hemoglobin hydrolysates from porcine blood obtained through enzymatic hydrolysis assisted by high hydrostatic pressure processing. Innov. Food Sci. Emerg. Technol. 2011, 12, 435–442. [Google Scholar] [CrossRef]
- Przybylski, R.; Bazinet, L.; Firdaous, L.; Kouach, M.; Goossens, J.-F.; Dhulster, P.; Nedjar, N. Harnessing slaughterhouse by-products: From wastes to high-added value natural food preservative. Food Chem. 2019, 304, 125448. [Google Scholar] [CrossRef]
- Crosby, W.H.; Munn, J.I.; Furth, F.W. Standardizing a method for clinical hemoglobinometry. United States Armed Forces Med. J. 1954, 5, 693–703. [Google Scholar]
- Vanhoute, M.; Firdaous, L.; Bazinet, L.; Froidevaux, R.; Lecouturier, D.; Guillochon, D.; Dhulster, P. Effect of haem on the fractionation of bovine haemoglobin peptic hydrolysate by electrodialysis with ultrafiltration membranes. J. Membr. Sci. 2010, 365, 16–24. [Google Scholar] [CrossRef]
- Sanchez-Reinoso, Z.; Cournoyer, A.; Thibodeau, J.; Ben Said, L.; Fliss, I.; Bazinet, L.; Mikhaylin, S. Effect of pH on the Antimicrobial Activity and Peptide Population of Pepsin Hydrolysates Derived from Bovine and Porcine Hemoglobins. ACS Food Sci. Technol. 2021, 1, 1687–1701. [Google Scholar] [CrossRef]
- Przybylski, R.; Bazinet, L.; Firdaous, L.; Kouach, M.; Goossens, J.-F.; Dhulster, P.; Nedjar-Arroume, N. Electroseparation of Slaughterhouse By-Product: Antimicrobial Peptide Enrichment by pH Modification. Membranes 2020, 10, 90. [Google Scholar] [CrossRef]
- Church, F.C.; Swaisgood, H.E.; Porter, D.H.; Catignani, G.L. Spectrophotometric Assay Using o-Phthaldialdehyde for Determination of Proteolysis in Milk and Isolated Milk Proteins. J. Dairy Sci. 1983, 66, 1219–1227. [Google Scholar] [CrossRef]
- Adler-Nissen, J. Enzymic Hydrolysis of Food Proteins; Elsevier Applied Science Publishers: Amsterdam, The Netherlands, 1986. [Google Scholar]
- Navarrete del Toro, M.A.; García-Carreño, F.L. Evaluation of the Progress of Protein Hydrolysis. Curr. Protoc. Food Anal. Chem. 2002, 10, B2.2.1–B2.2.14. [Google Scholar]
- Wang, G.; Li, X.; Wang, Z. APD3: The antimicrobial peptide database as a tool for research and education. Nucleic Acids Res. 2016, 44, D1087–D1093. [Google Scholar] [CrossRef] [PubMed]
- Fields, G.B.; Noble, R.L. Solid phase peptide synthesis utilizing 9-fluorenylmethoxycarbonyl amino acids. Int. J. Pept. Protein Res. 2009, 35, 161–214. [Google Scholar] [CrossRef]
- Sb Peptide—Synthesis & Engineering. Peptide Solubility Guidelines. SB PEPTIDE. Available online: https://www.sb-peptide.com/support/solubility/ (accessed on 11 October 2022).
- Vimont, A.; Fernandez, B.; Ahmed, G.; Fortin, H.-P.; Fliss, I. Quantitative antifungal activity of reuterin against food isolates of yeasts and moulds and its potential application in yogurt. Int. J. Food Microbiol. 2018, 289, 182–188. [Google Scholar] [CrossRef]
- Froidevaux, R.; Krier, F.; Nedjar-Arroume, N.; Vercaigne-Marko, D.; Kosciarz, E.; Ruckebusch, C.; Dhulster, P.; Guillochon, D. Antibacterial activity of a pepsin-derived bovine hemoglobin fragment. FEBS Lett. 2001, 491, 159–163. [Google Scholar] [CrossRef]
- Pfaller, M.A.; Sheehan, D.J.; Rex, J.H. Determination of Fungicidal Activities against Yeasts and Molds: Lessons Learned from Bactericidal Testing and the Need for Standardization. Clin. Microbiol. Rev. 2004, 17, 268–280. [Google Scholar] [CrossRef] [PubMed]
- Hsieh, M.H.; Yu, C.M.; Yu, V.L.; Chow, J.W. Synergy assessed by checkerboard a critical analysis. Diagn. Microbiol. Infect. Dis. 1993, 16, 343–349. [Google Scholar] [CrossRef]
- Deng, H.; Zheng, J.; Zhang, F.; Wang, Y.; Kan, J. Isolation of angiotensin I-converting enzyme inhibitor from pepsin hydrolysate of porcine hemoglobin. Eur. Food Res. Technol. 2014, 239, 933–940. [Google Scholar] [CrossRef]
- Dubois, V.; Nedjar-Arroume, N.; Guillochon, D. Influence of pH on the Appearance of Active Peptides in the Course of Peptic Hydrolysis of Bovine Haemoglobin. Prep. Biochem. Biotechnol. 2005, 35, 85–102. [Google Scholar] [CrossRef]
- Abou-Diab, M.; Thibodeau, J.; Deracinois, B.; Flahaut, C.; Fliss, I.; Dhulster, P.; Nedjar, N.; Bazinet, L. Bovine Hemoglobin Enzymatic Hydrolysis by a New Ecoefficient Process—Part I: Feasibility of Electrodialysis with Bipolar Membrane and Production of Neokyotophin (α137-141). Membranes 2020, 10, 257. [Google Scholar] [CrossRef] [PubMed]
- Koshland, D.E.; Haurowitz, F. “Protein”; Encyclopedia Britannica. 18 October 2022. Available online: https://www.britannica.com/science/protein (accessed on 9 November 2022).
- Lignot, B.; Froidevaux, R. Solvent Effect on Kinetics of Appearance of Neokyotorphin, VV-Haemorphin-4 and a Bradykinin-Potentiating Peptide in the Course of Peptic Hydrolysis of Bovine Haemoglobin. Biotechnol. Appl. Biochem. 1999, 30, 201–207. [Google Scholar]
- Žuvela, P.; Liu, J.J.; Wong, M.W.; Bączek, T. Prediction of Chromatographic Elution Order of Analytical Mixtures Based on Quantitative Structure-Retention Relationships and Multi-Objective Optimization. Molecules 2020, 25, 3085. [Google Scholar] [CrossRef] [PubMed]
- Catiau, L.; Traisnel, J.; Delval-Dubois, V.; Chihib, N.-E.; Guillochon, D.; Nedjar-Arroume, N. Minimal antimicrobial peptidic sequence from hemoglobin alpha-chain: KYR. Peptides 2011, 32, 633–638. [Google Scholar] [CrossRef] [PubMed]
- Powers, J.-P.S.; Hancock, R.E. The relationship between peptide structure and antibacterial activity. Peptides 2003, 24, 1681–1691. [Google Scholar] [CrossRef] [PubMed]
- UniProt. Consortium HBB—Hemoglobin Subunit Beta—Sus Scrofa (Pig)—HBB Gene & Protein. Available online: https://www.uniprot.org/uniprot/P02067 (accessed on 27 November 2019).
- van der Weerden, N.L.; Bleackley, M.R.; Anderson, M.A. Properties and mechanisms of action of naturally occurring antifungal peptides. Cell. Mol. Life Sci. 2013, 70, 3545–3570. [Google Scholar] [CrossRef] [PubMed]
- Nedjar-Arroume, N.; Dubois-Delval, V.; Miloudi, K.; Daoud, R.; Krier, F.; Kouach, M.; Briand, G.; Guillochon, D. Isolation and characterization of four antibacterial peptides from bovine hemoglobin. Peptides 2006, 27, 2082–2089. [Google Scholar] [CrossRef]
- Russell, A.D. Similarities and differences in the responses of microorganisms to biocides. J. Antimicrob. Chemother. 2003, 52, 750–763. [Google Scholar] [CrossRef]
- Matsuzaki, K. Why and how are peptide–lipid interactions utilized for self-defense? Magainins and tachyplesins as archetypes. Biochim. Biophys. Acta (BBA)-Biomembr. 1999, 1462, 1–10. [Google Scholar] [CrossRef]
- Palma-Guerrero, J.; Lopez-Jimenez, J.A.; Pérez-Berná, A.J.; Huang, I.-C.; Jansson, H.-B.; Salinas, J.; Villalaín, J.; Read, N.D.; Lopez-Llorca, L.V. Membrane fluidity determines sensitivity of filamentous fungi to chitosan. Mol. Microbiol. 2010, 75, 1021–1032. [Google Scholar] [CrossRef]
- Arzumanian, V.; Erofeeva, T.; Zhigalkina, P.; Ixanova, A.; Svitich, O. Activity of antimicrobial peptide fractions of human serum and saliva against clinically important yeasts. Curr. Top. Pept. Protein Res. 2019, 20, 9. [Google Scholar] [CrossRef]
- University of Nebraska. Antimicrobial Peptide Calculator and Predictor. Available online: https://aps.unmc.edu/prediction/predict (accessed on 22 June 2022).
- Soltani, S.; Keymanesh, K.; Sardari, S. In silico analysis of Antifungal Peptides: Determining the Lead Template Sequence of Potent antifungal peptides. Expert Opin. Drug Discov. 2007, 2, 837–847. [Google Scholar] [CrossRef] [PubMed]
- Shai, Y.; Oren, Z. From “carpet” mechanism to de-novo designed diastereomeric cell-selective antimicrobial peptides. Peptides 2001, 22, 1629–1641. [Google Scholar] [CrossRef] [PubMed]

| Strain | Subculture Conditions | References | Strain Collection | |
|---|---|---|---|---|
| Bacteria | Escherichia coli | TSB 1, 18 h, 37 °C (×2) | MC 4100 | Food microbiology laboratory (LMA), Laval University, Québec (QC) Canada |
| Listeria ivanovii | TSB, 18 h, 30 °C (×2) | HPB 28 | ||
| Filamentous Molds | Mucor racemosus | PDA 2, 7 days, 25 °C (×2) | LMA-722 | |
| Penicillium chrysogenum | LMA-212 | |||
| Aspergillus versicolor | LMA-370 | |||
| Paecilomyces spp. | 5332-9a | Denis Roy, Laval University | ||
| Yeasts | Rhodotorula mucilaginosa | PDB 3, 48 h, 25 °C (×2–3) | 27,173 | General Mills Yoplait, France |
| Saccharomyces boulardii | 27,169 | |||
| Kluyveromyces marxianus | 27,175 | |||
| Candida guilliermondii | 27,168 | |||
| Retention Time (min) | Molecular Mass (Da) | Chain | Location | Sequence * |
|---|---|---|---|---|
| 1.64 | 653.35 | α | 137–141 | TSKYR |
| 5.97 | 865.50 | α | 135–141 | VLTSKYR |
| 6.54 | 966.55 | α | 134–141 | TVLTSKYR |
| 6.67 | 1053.58 | α | 133–141 | STVLTSKYR |
| 8.45 | 1337.73 | α | 130–141 | ANVSTVLTSKYR |
| 10.36 | 1450.81 | α | 129–141 | LANVSTVLTSKYR |
| 12.01 | 1237.61 | α | 37–46 | PTTKTYFPHF |
| Retention Time (min) | Molecular Mass (Da) | Chain | Location | Sequence * |
|---|---|---|---|---|
| 4.57 | 767.41 | β | 142–147 | LAHKYH |
| 8.01 | 812.46 | α | 99–105 | KLLSHCL |
| 9.15 | 2633.37 | α | 1–28 | VLSAADKANVKAAWGKVGGQAGAHGAEA |
| 10.86 | 2746.44 | α | 1–29 | VLSAADKANVKAAWGKVGGQAGAHGAEAL |
| 10.93 | 925.54 | α | 99–106 | KLLSHCLL |
| 11.37 | 2417.17 | α | 107–128 | VTLAAHHPDDFNPSVHASLDKF |
| 12.14 | 3162.64 | α | 1–32 | VLSAADKANVKAAWGKVGGQAGAHGAEALERM |
| 16.46 | 1554.78 | α | 34–46 | LGFPTTKTYFPHF |
| 19.13 | 1701.85 | α | 33–46 | FLGFPTTKTYFPHF |
| 19.89 | 6681.47 | α | 37–98 | PTTKTYFPHFNLSHGSDQVKAHGQKVADALTKAVGHLDDLPGALSALSDLHAHKLRVDPVNF |
| 20.60 | 3214.64 | α | 107–136 | VTLAAHHPDDFNPSVHASLDKFLANVSTVL |
| 21.29 | 7145.68 | α | 33–98 | FLGFPTTKTYFPHFNLSHGSDQVKAHGQKVADALTKAVGHLDDLPGALSALSDLHAHKLRVDPVNF |
| Retention Time (min) | Molecular Mass (Da) | Chain | Location | Sequence | Total Hydrophobic Residues (%) 2 | Structure (%) 3 | Charge at pH 7 2 | Decrease (%) * |
|---|---|---|---|---|---|---|---|---|
| 5.97 | 865.501 | α | 135–141 | VLTSKYR | 29 | RC 100 | +2.0 | 10.1 |
| 9.34 | 1746.912 | α | 84–98 | SDLHAHKLRVDPVNF | 47 | RC 60 | +0.2 | 12.0 |
| 9.60 | 528.221 | β | 43–46 | FESF | 50 | RC 100 | −1.0 | 10.8 |
| 9.91 | 1537.760 | α | 25–38 | GAEALERMFLGFPT 1 | 50 | AH 30 | −1.0 | 38.0 |
| 1537.767 | β | 50–64 | SNADAVMGNPKVKAH 1 | 40 | RC 80 | +1.3 | ||
| 10.23 | 1859.997 | α | 83–98 | LSDLHAHKLRVDPVNF | 50 | RC 81 | +0.2 | 22.5 |
| 10.86 | 1244.689 | β | 129–141 | AAFQKVVAGVANA | 69 | AH 70 | +1.0 | 100.0 |
| 11.10 | 1867.032 | β | 125–143 | PNVQAAFQKVVAGVANALA 1 | 63 | AH 84 | +1.0 | 38.0 |
| 1867.057 | β | 100–116 | DPENFRLLGNVIVVVLA 1 | 58 | AH 47 | −1.0 | ||
| 1867.014 | α | 99–115 | KLLSHCLLVTLAAHHPD 1 | 52 | RC 70 | +0.8 | ||
| 2870.511 | β | 91–115 | ELHCDQLHVDPENFRLLGNVIVVVL 1 | 52 | RC 52 | −2.5 | 45.0 | |
| 11.50 | 2179.146 | α | 71–91 | GHLDDLPGALSALSDLHAHKL | 42 | AH 57 | −1.3 | 35.0 |
| 12.20 | 1200.493 | β | 43–53 | FESFGDLSNAD | 36 | RC 100 | −3.0 | 100.0 |
| 12.90 | 1848.883 | α | 104–120 | CLLVTLAAHHPDDFNPS 1 | 47 | RC 77 | −1.5 | 46.0 |
| 1848.904 | β | 45–62 | SFGDLSNADAVMGNPKVK 1 | 38 | RC 100 | 0 | ||
| 1848.937 | β | 71–87 | SFSDGLKHLDNLKGTFA 1 | 35 | AH 53 | +0.3 | ||
| 15.89 | 3461.789 | α | 47–80 | NLSHGSDQVKAHGQKVADALTKAVGHLDDLPGAL | 41 | AH 68 | −0.7 | 16.6 |
| 16.27 | 898.436 | α | 30–36 | ERMFLGF | 57 | AH 43 | 0 | 17.5 |
| 16.65 | 1307.706 | β | 33–42 | LVVYPWTQRF | 60 | AH 60 | +1.0 | 11.6 |
| 16.84 | 1968.038 | β | 14–32 | GLWGKVNVDEVGGEALGRL | 42 | AH 79 | −1.0 | 49.9 |
| 17.16 | 1720.924 | β | 98–112 | HVDPENFRLLGNVIV | 46 | RC 40 | −0.8 | 25.0 |
| 17.35 | 4681.402 | α | 37–80 | PTTKTYFPHFNLSHGSDQVKAHGQKVADALTKAVGHLDDLPGAL | 34 | AH 52 | +1.0 | 100.0 |
| 17.60 | 1011.521 | α | 29–36 | LERMFLGF | 63 | RC 63 | 0 | 20.4 |
| 17.99 | 1988.996 | α | 31–46 | RMFLGFPTTKTYFPHF | 50 | RC 88 | +2.1 | 22.6 |
| 18.24 | 2118.036 | α | 30–46 | ERMFLGFPTTKTYFPHF | 47 | RC 100 | +1.1 | 19.8 |
| 19.00 | 1420.785 | β | 32–42 | LLVVYPWTQRF | 64 | RC 55 | +1.0 | 47.3 |
| 19.96 | 5269.722 | α | 34–83 | LGFPTTKTYFPHFNLSHGSDQVKAHGQKVADALTKAVGHLDDLPGALSAL | 38 | AH 60 | +1.0 | 100.0 |
| 20.02 | 1227.766 | β | 104–114 | FRLLGNVIVVV | 72 | RC 46 | +1.0 | 46.0 |
| 20.78 | 5267.677 | α | 37–86 | PTTKTYFPHFNLSHGSDQVKAHGQKVADALTKAVGHLDDLPGALSALSDL | 36 | AH 60 | 0 | 100.0 |
| 21.87 | 2845.597 | β | 104–128 | FRLLGNVIVVVLARRLGHDFNPNVQ | 52 | RC 50 | +2.3 | 100.0 |
| 21.99 | 2032.146 | β | 98–115 | HVDPENFRLLGNVIVVVL | 61 | RC 72 | −1.0 | 63.9 |
| 22.12 | 3087.608 | β | 16–42 | WGKVNVDEVGGEALGRLLVVYPWTQRF | 44 | RC 60 | 0 | 100.0 |
| 22.57 | 5698.005 | α | 91–141 | LRVDPVNFKLLSHCLLVTLAAHHPDDFNPSVHASLDKFLANVSTVLTSKYR | 45 | AH 60 | +2.0 | 100.0 |
| 23.2 | 3678.966 | β | 98–130 | HVDPENFRLLGNVIVVVLARRLGHDFNPNVQAA | 48 | AH 52 | +0.5 | 92.0 |
| 23.26 | 3536.894 | β | 98–128 | HVDPENFRLLGNVIVVVLARRLGHDFNPNVQ | 45 | RC 61 | +0.5 | 90.0 |
| 23.33 | 3607.928 | β | 98–129 | HVDPENFRLLGNVIVVVLARRLGHDFNPNVQA | 53 | RC 72 | +0.2 | 100.0 |
| 24.73 | 4035.127 | β | 95–130 | DQLHVDPENFRLLGNVIVVVLARRLGHDFNPNVQAA | 47 | RC 56 | −0.5 | 100.0 |
| 24.79 | 3893.056 | β | 95–128 | DQLHVDPENFRLLGNVIVVVLARRLGHDFNPNVQ | 44 | AH 50 | −0.5 | 100.0 |
| 26.38 | 4270.106 | β | 16–53 | WGKVNVDEVGGEALGRLLVVYPWTQRFFESFGDLSNAD | 42 | RC 53 | −3.0 | 100.0 |
| 26.45 | 4155.071 | β | 16–52 | WGKVNVDEVGGEALGRLLVVYPWTQRFFESFGDLSNA | 43 | RC 57 | −2.0 | 100.0 |
| 26.51 | 5512.961 | β | 98–147 | HVDPENFRLLGNVIVVVLARRLGHDFNPNVQAAFQKVVAGVANALAHKYH | 50 | AH 78 | +3.0 | 100.0 |
| Strains | Strain No. | Raw Hydrolysate | Discolored Hydrolysate | Pellet from Discoloration | |
|---|---|---|---|---|---|
| Bacteria | E. coli | MC4100 | − | − | n/a |
| L. ivanovii | HPB28 | − | − | n/a | |
| Yeasts | R. mucilaginosa | 27173 | +++ | +++ | ++ |
| C. guilliermondii | 27168 | ++ | + | − | |
| S. boulardii | 27169 | + | + | − | |
| K. marxianus | 27175 | ++ | ++ | + | |
| Molds | M. racemosus | LMA–722 | ++ | ++ | + |
| P. chrysogenum | LMA–212 | + | − | − | |
| A. versicolor | LMA–370 | − | − | − | |
| Paecilomyces spp. | 5332–9a | +++ | +++ | ++ |
| Strain | mg/mL | Hydrolysate | ||
|---|---|---|---|---|
| Raw | Discolored | Pellet | ||
| S. boulardii | MIC | 2.9 ± 0.0 a | 30.0 ± 0.0 b | >40± 0.0 c |
| MFC | 5.9 ± 0.6 a | 40.0 ± 0.0 b | n.d. | |
| MFC/MIC Ratio | 2.0 | 1.3 | n.d. | |
| C. guilliermondii | MIC | 2.5 ± 0.0a | >40.0 ± 0.0 b | >40.0 ± 0.0 b |
| MFC | 3.8 ± 0.0 | n.d. | n.d. | |
| MFC/MIC Ratio | 1.5 | n.d. | n.d. | |
| K. marxianus | MIC | 2.1 ± 0.0 a | 5.8 ± 0.0 c | 2.5 ± 0.0 b |
| MFC | 5.6 ± 1.3 a | 7.8 ± 2.6 b | 10.0 ± 0.0 c | |
| MFC/MIC Ratio | 2.7 | 1.3 | 4.0 | |
| R. mucilaginosa | MIC | 0.3 ± 0.0 a | 0.5 ± 0.2 a | 0.8 ± 0.0 b |
| MFC | 0.3 ± 0.0 a | 0.5 ± 0.2 a | 1.3 ± 0.0 b | |
| MFC/MIC Ratio | 1.0 | 1.0 | 1.5 | |
| M. racemosus | MIC | 0.7 ± 0.2 a | 8.9 ± 2.9 c | 4.7 ± 0.5 b |
| MFC | 0.8 ± 0.4 a | 8.9 ± 2.9 c | 5.0 ± 0.0 b | |
| MFC/MIC Ratio | 1.1 | 1.0 | 1.1 | |
| Paecilomyces spp. | MIC | 0.1 ± 0.0 a | 0.1 ± 0.0 a | 0.7 ± 0.1 b |
| MFC | 0.1 ± 0.0 a | 0.1 ± 0.0 a | 0.7 ± 0.1 b | |
| MFC/MIC Ratio | 1.0 | 1.0 | 1.0 | |
| P. chrysogenum | MIC | 12.5 ± 0.0 a | >40.0 ± 0.0 b | >40.0 ± 0.0 b |
| MFC | 12.5 ± 0.0 | n.d. | n.d. | |
| MFC/MIC Ratio | 1.0 | n.d. | n.d. | |
| A. versicolor | MIC | >40.0 ± 0.0 a | >40.0 ± 0.0 a | >40.0 ± 0.0 a |
| MFC | n.d. | n.d. | n.d. | |
| MFC/MIC Ratio | n.d. | n.d. | n.d. | |
| Sequence (Amino Acids) | R. mucilaginosa (mM) | Paecilomyces spp. (mM) | |
|---|---|---|---|
| LAHKYH | MIC | 1.3 ± 0.0 | 1.3 ± 0.0 |
| MFC | 1.3 ± 0.0 | 1.3 ± 0.0 | |
| MFC/MIC | 1.0 | 1.0 | |
| NALAHKYH | MIC | 0.3 ± 0.0 | 0.2 ± 0.0 |
| MFC | 0.3 ± 0.0 | 0.3 ± 0.0 | |
| MFC/MIC | 1.0 | 2.0 | |
| FRLLGNVIVVV | MIC | 0.2 ± 0.0 | 0.6 ± 0.0 |
| MFC | 0.3 ± 0.0 | 0.6 ± 0.0 | |
| MFC/MIC | 2.0 | 1.0 | |
| HVDPENFRLLGNVIVVVL | MIC | 0.10 ± 0.05 | >1.3 ± 0.0 |
| MFC | 0.3 ± 0.1 | n.d. | |
| MFC/MIC | 2.0 | n.d. | |
| DQLHVDPENFRLLGNVIVVVLARRLGHDFNPNVQAA | MIC | 1.3 ± 0.0 | 1.3 ± 0.0 |
| MFC | 1.3 ± 0.0 | 1.3 ± 0.0 | |
| MFC/MIC | 1.0 | 1.0 | |
| GHLDDLPGALSALSDLHAHKL | MIC | 0.6 ± 0.0 | 1.3 ± 0.0 |
| MFC | 0.6 ± 0.0 | 1.7 ± 0.7 | |
| MFC/MIC | 1.0 | 0.8 | |
| PTTKTYFPHFNLSHGSDQVKAHGQKVADALTKAVGHLDDLPGAL | MIC | 0.3 ± 0.0 | 0.05 ± 0.02 |
| MFC | 0.3 ± 0.0 | 0.07 ± 0.00 | |
| MFC/MIC | 1.0 | 1.0 | |
| HVDPENFRLLGNVIVVVLARRLGHDFNPNVQAAFQKVVAGVANALAHKYH | MIC | 0.8 ± 0.4 | 0.8 ± 0.4 |
| MFC | 0.8 ± 0.4 | 1.3 ± 0.0 | |
| MFC/MIC | 1.0 | 1.3 |
Publisher’s Note: MDPI stays neutral with regard to jurisdictional claims in published maps and institutional affiliations. |
© 2022 by the authors. Licensee MDPI, Basel, Switzerland. This article is an open access article distributed under the terms and conditions of the Creative Commons Attribution (CC BY) license (https://creativecommons.org/licenses/by/4.0/).
Share and Cite
Cournoyer, A.; Thibodeau, J.; Ben Said, L.; Sanchez-Reinoso, Z.; Mikhaylin, S.; Fliss, I.; Bazinet, L. How Discoloration of Porcine Cruor Hydrolysate Allowed the Identification of New Antifungal Peptides. Foods 2022, 11, 4035. https://doi.org/10.3390/foods11244035
Cournoyer A, Thibodeau J, Ben Said L, Sanchez-Reinoso Z, Mikhaylin S, Fliss I, Bazinet L. How Discoloration of Porcine Cruor Hydrolysate Allowed the Identification of New Antifungal Peptides. Foods. 2022; 11(24):4035. https://doi.org/10.3390/foods11244035
Chicago/Turabian StyleCournoyer, Aurore, Jacinthe Thibodeau, Laila Ben Said, Zain Sanchez-Reinoso, Sergey Mikhaylin, Ismail Fliss, and Laurent Bazinet. 2022. "How Discoloration of Porcine Cruor Hydrolysate Allowed the Identification of New Antifungal Peptides" Foods 11, no. 24: 4035. https://doi.org/10.3390/foods11244035
APA StyleCournoyer, A., Thibodeau, J., Ben Said, L., Sanchez-Reinoso, Z., Mikhaylin, S., Fliss, I., & Bazinet, L. (2022). How Discoloration of Porcine Cruor Hydrolysate Allowed the Identification of New Antifungal Peptides. Foods, 11(24), 4035. https://doi.org/10.3390/foods11244035

